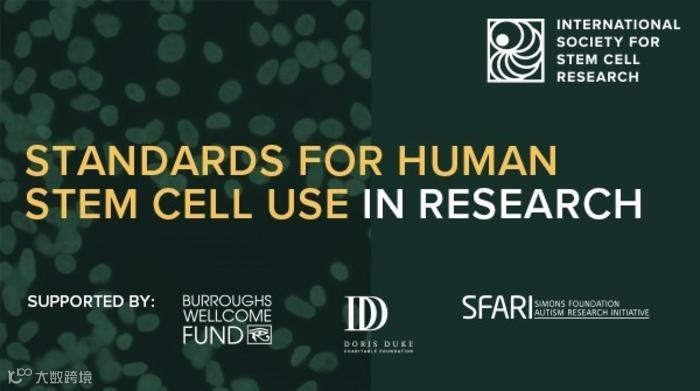

一般来说,在人多能干细胞研究过程中需重点关注基因组完整性、多能性、基因和标记表达、表观遗传以及培养系统和形态学特征。2023年6月,国际干细胞研究协会(ISSCR)颁发了一项关于PSC质量标准评估指导原则的文件(下文简称指导原则)。指导原则中对于多能性和未分化状态的评估、遗传状态的评估以及干细胞模型系统等都有详细的描述。
图1 PSC质量标准评估指导原则
如指导原则中所述,多能性是一种功能特性,意味着单个细胞能够分化成生物体的所有体细胞类型。一个细胞系只有在实验中被证明能够分化为代表发育中的生物体体细胞谱系的所有三个胚层细胞时,才被认定具有多能性。

图2 hPSC细胞系的状态和研究目的影响其未分化状态以及多能性潜力的鉴定:以往发表的hPSC细胞系(左)比新细胞系或新培养或重编程系统(右)需要更少的鉴定步骤
许多细胞很少或几乎没有分化能力,表达许多未分化细胞的标志物。这些标志物和基因表达谱可用于指示未分化状态。通过特定的基因表达对干细胞发育状态进行评估,如利用流式细胞分析、高通量筛选、活细胞成像以及单细胞组学等方式在多个时间点上进行评估。
近期,Stem Cell Reports和ISSCR共同制作了一款挂图。挂图中清楚地罗列出人多能干细胞和组织干细胞成果发表的规范,并将其对应到指导原则中的不同章节,是研究过程中必不可少的参考资料。

图3 PSC质量标准评估指导原则挂图
-
了解如何按照PSC质量标准评估指导原则来规划和开展基于hPSC的研究 -
快速查找PSC质量标准评估指导原则的相关部分 -
了解相关资源和免费培训


左右滑动查看更多
图4 运用挂图可快速查找指导原则中的相关内容(部分展示)
挂图中提到有关hPSC的多能性和未分化状态的鉴定,如测定方法、定量结果以及统计分析以及与关键实验相关的分析时间等内容,人类细胞的多能性应通过评估分化能力的实验来证明,通过定量测量外胚层、内胚层和中胚层的标志物组合的诱导情况,以及未分化状态标志物的缺失情况来验证分化能力。
- END -
About
关于睿捷生物科技有限公司
睿捷生物科技有限公司是 (realgen-bio Co., Ltd.,简称睿捷生物)致力于为国内生命科学领域提供先进、专业的仪器设备、试剂耗材的企业。公司目前是近20家国际知名生物公司的一级代理商,为客户提供从研发到生产的各类实验室仪器,检测试剂和生产设备。
公司产品领域涵盖分子生物学、免疫学、血液学、肿瘤研究、信号通路、药物筛选、干细胞研究、神经生物学、表观遗传学等等,为用户提供系统性的科学研究完整解决方案,成为众多研究者们可以信赖的选择。
公司成立于2011年,总部位于苏州,在南京、济南、合肥都设有办事处,公司客户主要为国内领先的生物制药、细胞治疗、生物医学和各类生物技术公司,以及大量的生命科学基础研究和政府实验室,目前已服务客户单位5000余家。


睿捷-企业文化
公司的使命:高效服务客户、为客户持续创造价值
公司的愿景:将人与科技相结合,成为生命科学领域一流的解决方案供应商。
公司的价值观:诚信、公开、坚持、分享
睿捷-合作伙伴








